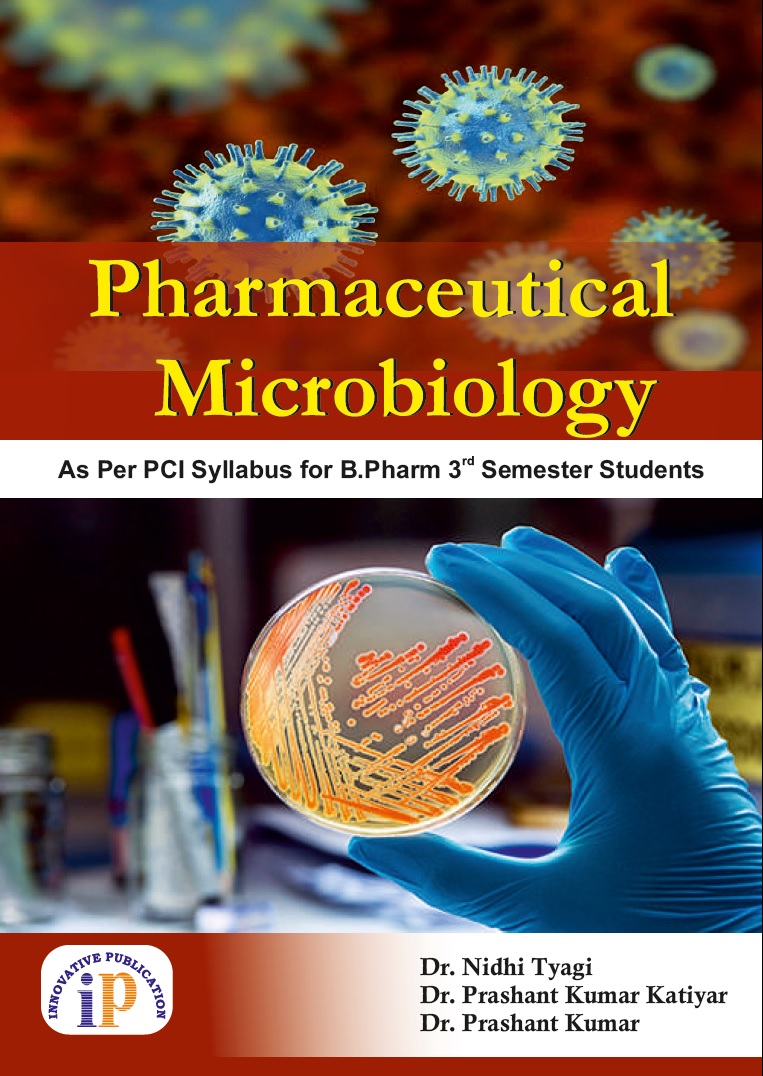

₹475
₹428
|
$25.00
$22.50
Author Details: Dr. Nidhi Tyagi, Dr. Prashant Kumar Katiyar, Dr. Prashant Kumar
Add to cart

₹550
₹495
|
$30.00
$27.00
Author Details: Dr. Rohit Shankar Mane
Add to cart
2025 © All rights reserved by 🔗 IP Innovative Publication Pvt. Ltd.